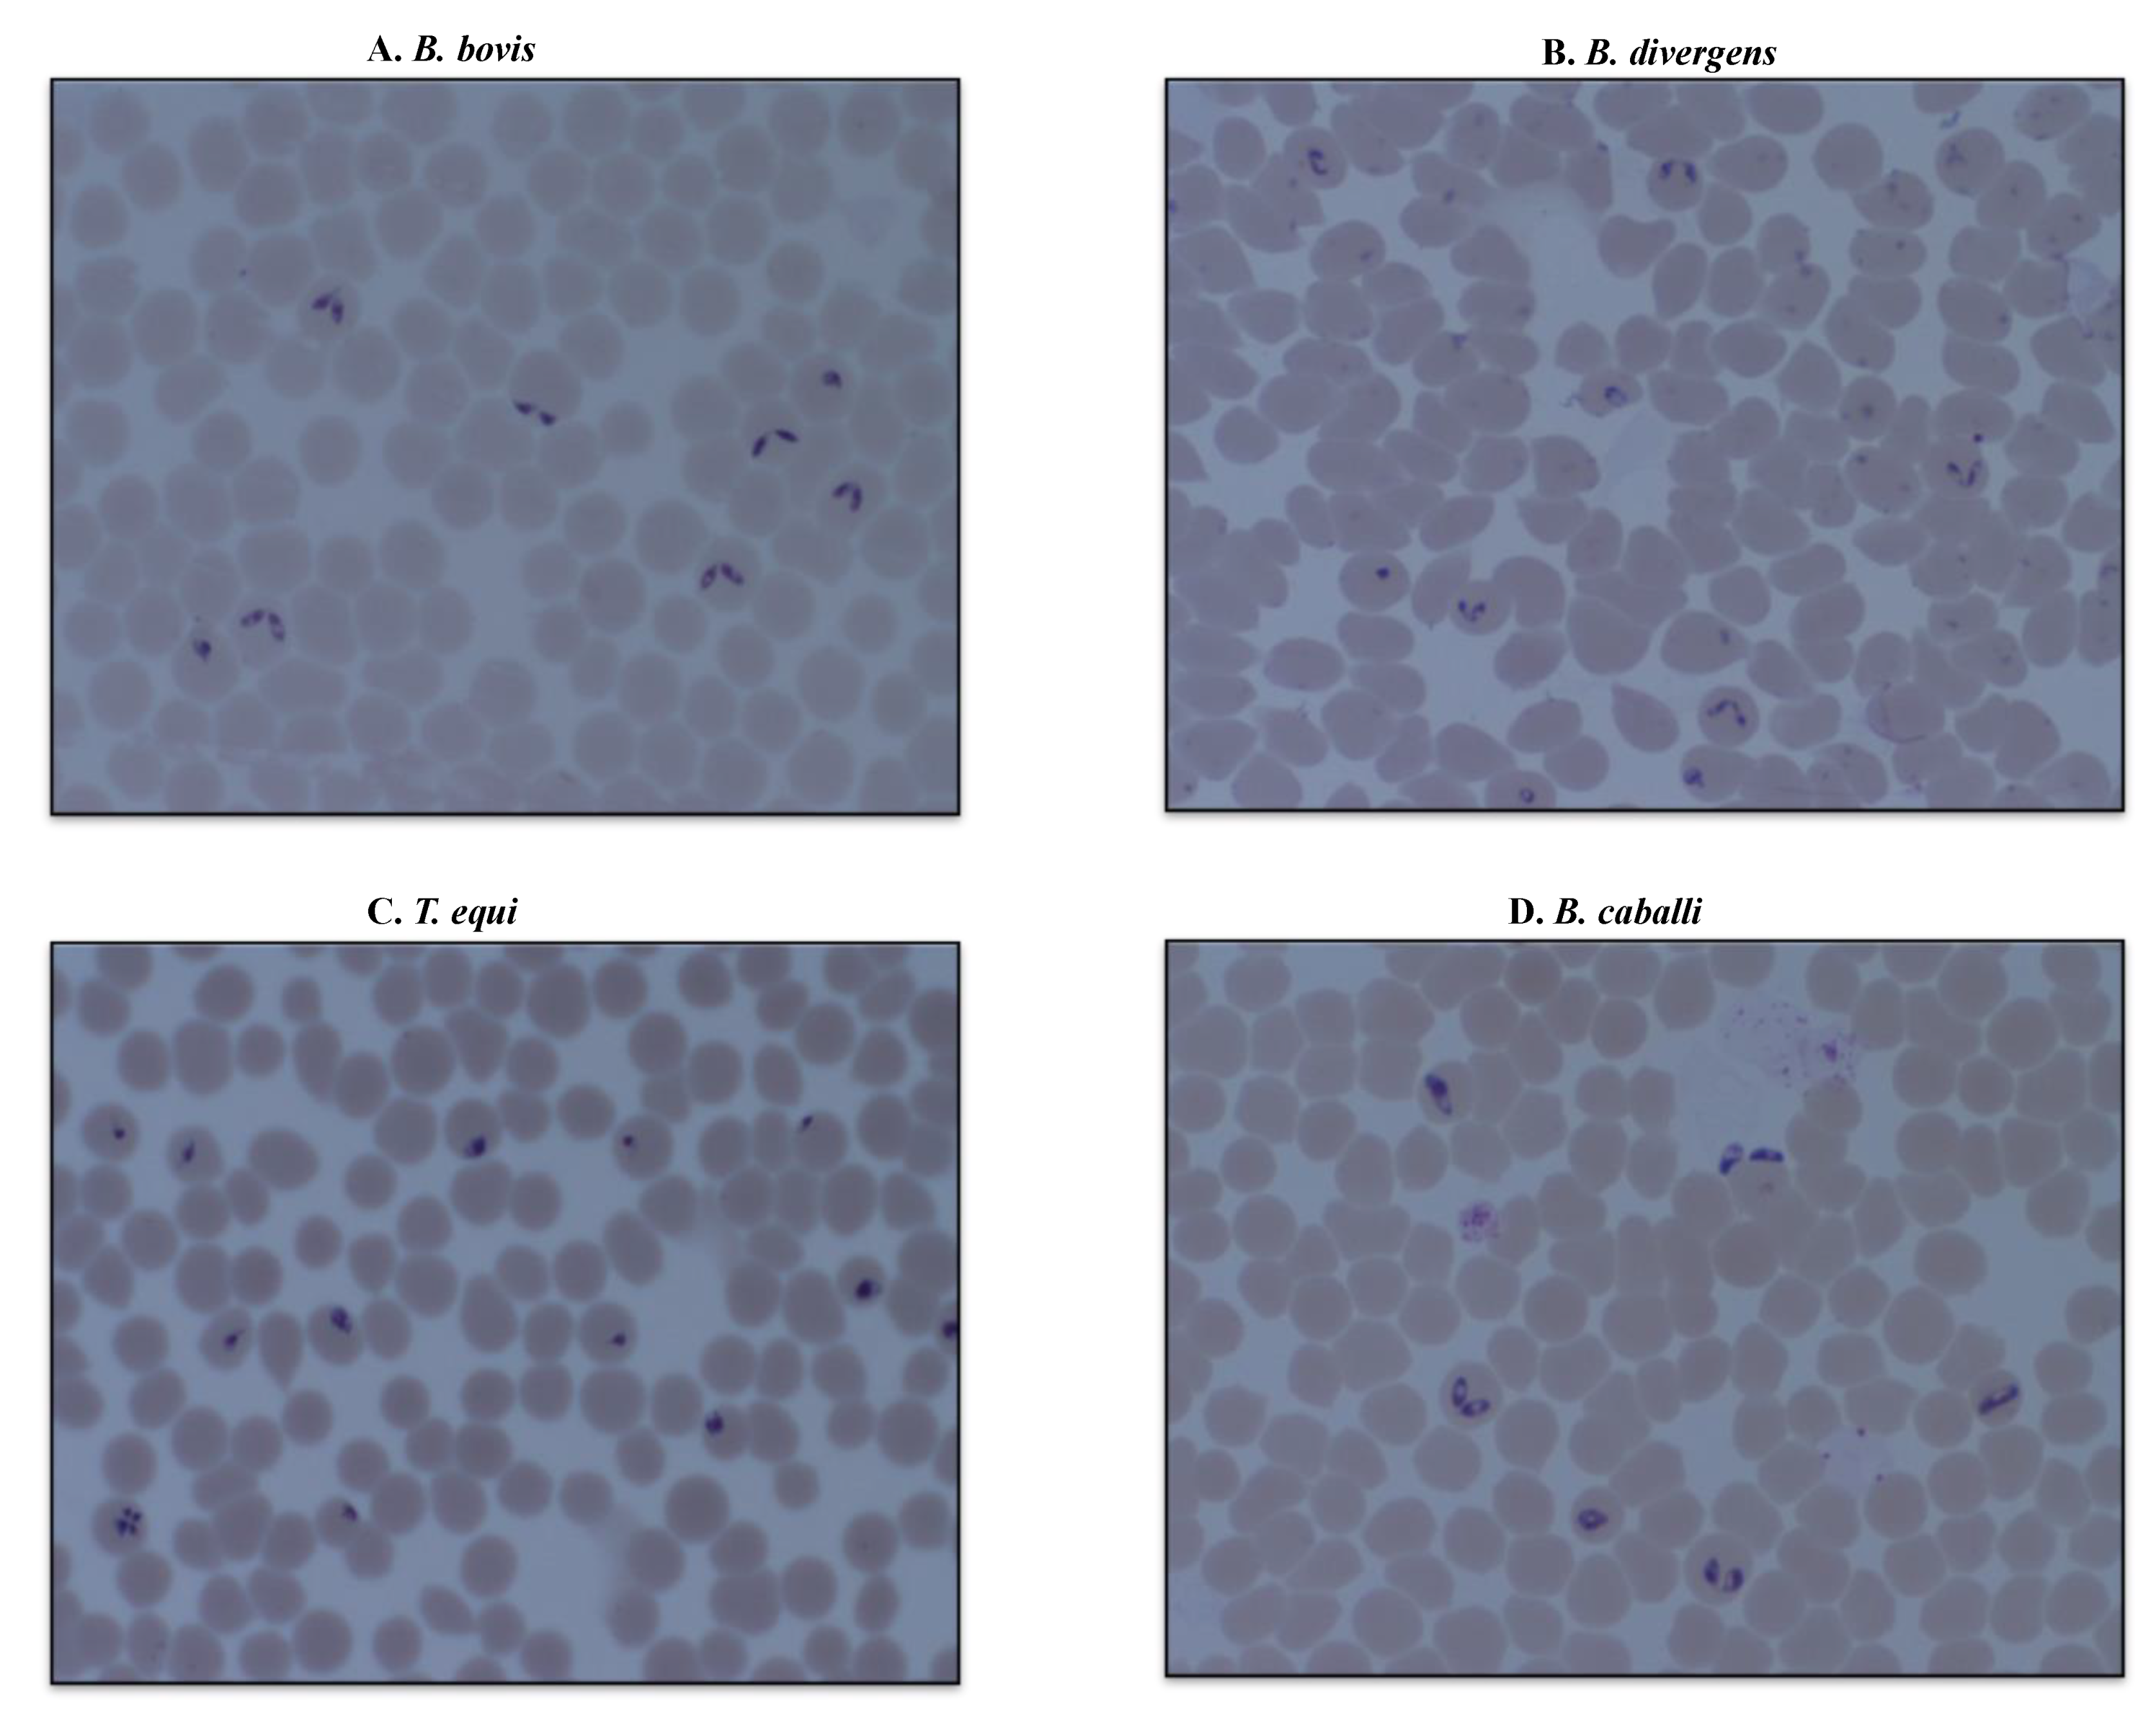
Parasitologia 01 00020 g003 Parasitologia 01 00020 g003

Effects of Methanolic Extract from Turmeric (Curcuma longa) against the In Vitro Multiplication of Several Babesia Species and Theileria equi
Abstract
1. Introduction
2. Results
2.1. Turmeric Inhibits the Development of Babesia and Theileria In Vitro
2.2. DA Improves the In Vitro Efficacy of Turmeric Methanolic Extract
3. Discussion
4. Materials and Methods
4.1. Chemical Reagents
4.2. Turmeric Methanolic Extract Preparation
4.3. Determination of the Toxic Effect of Turmeric Methanolic Extract on Host Erythrocytes
4.4. In Vitro Growth Inhibition Assay
4.5. Viability Test
4.6. The Combination of Turmeric and Anti-babesial Drugs In Vitro
4.7. Statistical Analysis
Author Contributions
Funding
Institutional Review Board Statement
Informed Consent Statement
Data Availability Statement
Acknowledgments
Conflicts of Interest
Appendix A
| Drug | IC50 Values (µg/mL) a |
|---|---|
| DA | |
| B. bovis | 0.16 ± 0.02 |
| B. divergens | 0.08 ± 0.003 |
| T. equi | 0.28 ± 0.01 |
| B. caballi | 0.012 ± 0.003 |
References
- Rizk, M.A.; El-Sayed, S.A.E.; El-Khodery, S.; Yokoyama, N.; Igarashi, I. Discovering the in vitro potent inhibitors against Babesia and Theileria parasites by repurposing the Malaria Box: A review. Vet. Parasitol. 2019, 274, 108895. [Google Scholar] [CrossRef]
- El-Sayed, S.A.E.S.; Rizk, M.A.; Terkawi, M.A.; Mousa, A.; El Said, E.S.E.S.; Elsayed, G.; Fouda, M.; Yokoyama, N.; Igarashi, I. Cocktail of Theileria equi antigens for detecting infection in equines. Asian Pac. J. Trop. Biomed. 2015, 5, 977–981. [Google Scholar] [CrossRef]
- Silva, M.G.; Bastos, R.G.; Stone Doggett, J.; Riscoe, M.K.; Pou, S.; Winter, R.; Dodean, R.A.; Nilsen, A.; Suarez, C.E. Endochin-like quinolone-300 and ELQ-316 inhibit Babesia bovis, B. bigemina, B. caballi and Theileria equi. Parasit. Vectors 2020, 13, 606. [Google Scholar] [CrossRef]
- Silva, M.G.; Villarino, N.F.; Knowles, D.P.; Suarez, C.E. Assessment of Draxxin ® (tulathromycin) as an inhibitor of in vitro growth of Babesia bovis, Babesia bigemina and Theileria equi. Int. J. Parasitol. Drugs Drug Resist. 2018, 8, 265–270. [Google Scholar] [CrossRef] [PubMed]
- Rizk, M.A.; AbouLaila, M.; El-Sayed, S.A.E.; Guswanto, A.; Yokoyama, N.; Igarashi, I. Inhibitory effects of fluoroquinolone antibiotics on Babesia divergens and Babesia microti, blood parasites of veterinary and zoonotic importance. Infect. Drug Resist. 2018, 11, 1605–1615. [Google Scholar] [CrossRef] [PubMed]
- Tuvshintulga, B.; AbouLaila, M.; Sivakumar, T.; Tayebwa, D.S.; Gantuya, S.; Naranbaatar, K.; Ishiyama, A.; Iwatsuki, M.; Otoguro, K.; Ōmura, S.; et al. Chemotherapeutic efficacies of a clo- fazimine and diminazene aceturate combination against piroplasm parasites and their AT-rich DNA-binding activity on Babesia bovis. Sci. Rep. 2017, 7, 13888. [Google Scholar] [CrossRef] [PubMed]
- Van Voorhis, W.C.; Adams, J.H.; Adelfio, R.; Ahyong, V.; Akabas, M.H.; Alano, P.; Alday, A.; Aleman Resto, Y.; Alsibaee, A.; Alzualde, A.; et al. Open Source Drug Discovery with the Malaria Box Compound Collection for Neglected Diseases and Beyond. PLoS Pathog. 2016, 12, e1005763. [Google Scholar] [CrossRef]
- Rizk, M.A.; El-Sayed, S.A.E.; Nassif, M.; Mosqueda, J.; Xuan, X.; Igarashi, I. Assay methods for in vitro and in vivo anti-Babesia drug efficacy testing: Current progress, outlook, and challenges. Vet. Parasitol. 2020, 279, 109013. [Google Scholar] [CrossRef]
- Mosqueda, J.; Olvera-Ramirez, A.; Aguilar-Tipacamu, G.; Canto, G.J. Current advances in detection and treatment of babesiosis. Curr. Med. Chem. 2012, 19, 1504–1518. [Google Scholar] [CrossRef]
- Vaughn, A.R.; Branum, A.; Sivamani, R.K. Effects of Turmeric (Curcuma longa) on Skin Health: A Systematic Review of the Clinical Evidence. Phytother. Res. 2016, 30, 1243–1264. [Google Scholar] [CrossRef]
- Chakrabarti, R.; Rawat, P.S.; Cooke, B.M.; Coppel, R.L.; Patankar, S. Cellular effects of curcumin on Plasmodium falciparum include disruption of microtubules. PLoS ONE 2013, 8, e57302. [Google Scholar] [CrossRef] [PubMed]
- Hussein, A.; Rashed, S.; El Hayawan, I.; El-Sayed, R.; Ali, H. Evaluation of the Anti-schistosomal Effects of Turmeric (Curcuma longa) Versus Praziquantel in Schistosoma mansoni Infected Mice. Iran. J. Parasitol. 2017, 12, 587–596. [Google Scholar]
- Shahiduzzaman, M.; Dyachenko, V.; Khalafalla, R.E.; Desouky, A.Y.; Daugschies, A. Effects of curcumin on Cryptosporidium parvum in vitro. Parasitol. Res. 2009, 105, 1155–1161. [Google Scholar] [CrossRef] [PubMed]
- Salama, A.A.; AbouLaila, M.; Terkawi, M.A.; Mousa, A.; El-Sify, A.; Allaam, M.; Zaghawa, A.; Yokoyama, N.; Igarashi, I. Inhibitory effect of allicin on the growth of Babesia and Theileria equi parasites. Parasitol. Res. 2014, 113, 275–283. [Google Scholar] [CrossRef] [PubMed]
- Salama, A.A.; Aboulaila, M.; Moussa, A.A.; Nayel, M.A.; El-Sify, A.; Terkawi, M.A.; Hassan, H.Y.; Yokoyama, N.; Igarashi, I. Evaluation of in vitro and in vivo inhibitory effects of fusidic acid on Babesia and Theileria parasites. Vet. Parasitol. 2013, 191, 1–10. [Google Scholar] [CrossRef] [PubMed]
- El-Sayed, S.A.E.; Rizk, M.A.; Yokoyama, N.; Igarashi, I. Evaluation of the in vitro and in vivo inhibitory effect of thymoquinone on piroplasm parasites. Parasit. Vectors 2019, 12, 37. [Google Scholar] [CrossRef]
- Rizk, M.A.; El-Sayed, S.A.; Terkawi, M.A.; Youssef, M.A.; El Said el Sel, S.; Elsayed, G.; El-Khodery, S.; El-Ashker, M.; Elsify, A.; Omar, M.; et al. Optimization of a Fluorescence-Based Assay for Large-Scale Drug Screening against Babesia and Theileria Parasites. PLoS ONE 2015, 10, e0125276. [Google Scholar] [CrossRef]
- Rizk, M.A.; El-Sayed, S.A.; AbouLaila, M.; Tuvshintulga, B.; Yokoyama, N.; Igarashi, I. Large-scale drug screening against Babesia divergens parasite using a fluorescence-based high-throughput screening assay. Vet. Parasitol. 2016, 227, 93–97. [Google Scholar] [CrossRef]
- AbouLaila, M.; El-Sayed, S.A.E.; Omar, M.A.; Al-Aboody, M.S.; Aziz, A.R.A.; Abdel-Daim, M.M.; Rizk, M.A.; Igarashi, I. Myrrh Oil in Vitro Inhibitory Growth on Bovine and Equine Piroplasm Parasites and Babesia microti of Mice. Pathogens 2020, 9, 173. [Google Scholar] [CrossRef]
- Wolfensohn, S.E.; Lloyd, M.H. Aleutian disease in laboratory ferrets. Vet. Rec. 1994, 134, 100. [Google Scholar] [CrossRef]
- Al-Asmari, A.K.; Albalawi, S.M.; Athar, M.T.; Khan, A.Q.; Al-Shahrani, H.; Islam, M. Moringa oleifera as an Anti-Cancer Agent against Breast and Colorectal Cancer Cell Lines. PLoS ONE 2015, 10, e0135814. [Google Scholar] [CrossRef] [PubMed]
- Kamkar Asl, M.; Nazariborun, A.; Hosseini, M. Analgesic effect of the aqueous and ethanolic extracts of clove. Avicenna J. Phytomed. 2013, 3, 186–192. [Google Scholar]
- Rizk, M.A.; El-Sayed, S.A.E.; Igarashi, I. Evaluation of the inhibitory effect of Zingiber officinale rhizome on Babesia and Theileria parasites. Parasitol. Int. 2021, 85, 102431. [Google Scholar] [CrossRef] [PubMed]
- Hines, S.A.; Palmer, G.H.; Jasmer, D.P.; McGuire, T.C.; McElwain, T.F. Neutralization-sensitive merozoite sur- face antigens of Babesia bovis encoded by members of a polymorphic gene family. Mol. Biochem. Para- sitol. 1992, 55, 85–94. [Google Scholar] [CrossRef]
- Avarzed, A.; Igarashi, I.; Kanemaru, T.; Hirumi, K.; Omata, Y.; Saito, A.; Oyamada, T.; Nagasawa, H.; Toyoda, Y.; Suzuki, N. Improved in vitro cultivation of Babesia caballi. J. Vet. Med. Sci. 1997, 59, 479–481. [Google Scholar] [CrossRef] [PubMed]
- Hirata, H.; Ikadai, H.; Yokoyama, N.; Xuan, X.; Fujisaki, K.; Suzuki, N.; Mikami, T.; Igarashi, I. Cloning of a truncated Babesia equi gene encoding an 82-kilodalton protein and its potential use in an enzyme-linked immunosorbent assay. J. Clin. Microbiol. 2002, 40, 1470–1474. [Google Scholar] [CrossRef] [PubMed][Green Version]

| Organism | IC50 (mg/mL) a |
|---|---|
| B. bovis | 0.830 ± 0.078 |
| B. divergens | 0.375 ± 0.055 |
| T. equi | 1.405 ± 0.575 |
| B. caballim | 0.720 ± 0.090 |
| Parasite | Drug Concentrations (mg/mL) a | |||||
|---|---|---|---|---|---|---|
| 0.5 | 1.0 | 10 | 25 | 50 | 100 | |
| B. bovis | + | + | - | - | - | - |
| B. divergens | + | - | - | - | - | - |
| T. equi | + | + | - | - | - | - |
| B. caballi | + | + | - | - | - | - |
| Drug | Drug Concentrations (μM) a | ||||
|---|---|---|---|---|---|
| 10 | 5 | 1 | 0.5 | 0.25 | |
| B. bovis | - | - | - | - | - |
| B. divergens | - | - | - | - | - |
| T. equi | - | - | - | - | - |
| B. caballi | - | - | - | - | - |
| Group | The Emitted Fluorescence Signal (Mean ± SD) | |||
|---|---|---|---|---|
| B. bovis | B. divergens | T. equi | B. caballi | |
| Control | 271.11 ± 8.22 | 235.13 ± 10.23 | 331.15 ± 14.18 | 288.11 ± 6.75 |
| DA IC50 | 123.01 ± 3.20 | 121.11 ± 8.09 | 153.21 ± 6.70 | 120.03 ± 4.98 |
| M1 (¾:¾) | 20.33 ± 3.11 ** | 15.71 ± 3.11 ** | 11.11 ± 2.02 ** | 51.11 ± 5.76 ** |
| M2 (¾:½) | 37.22 ± 5.33 ** | 20.98 ± 5.34 ** | 17.14 ± 5.35 ** | 45.81 ± 6.11 ** |
| M3 (½:¾) | 44.33 ± 3.21 ** | 143.66 ± 10.13 * | 15.66 ± 5.32 ** | 51.02 ± 4.32 ** |
| M4 (½:½) | 42.28 ± 3.87 ** | 155.17 ± 11.34 * | 19.18 ± 3.76 ** | 76.12 ± 7.35 ** |
| M5 (¼:¾) | 80.51± 4.99 ** | 141.33 ± 7.43 * | 25.22 ± 5.88 ** | 81.97 ± 8.61 ** |
| M6 (¼:½) | 185.48 ± 11.85 * | 144.13 ± 6.43 * | 31.33 ± 6.45 ** | 87.14 ± 4.32 ** |
| M7 (1/8:¾) | 172.33 ± 8.09 * | 159.12 ± 12.35 * | 156.29 ± 8.21 * | 94.11 ± 8.24 ** |
| M8 (1/8:½) | 198.32 ± 11.02 * | 162.15 ± 11.29 * | 166.55 ± 9.91 * | 95.09 ± 4.51 ** |
Publisher’s Note: MDPI stays neutral with regard to jurisdictional claims in published maps and institutional affiliations. |
© 2021 by the authors. Licensee MDPI, Basel, Switzerland. This article is an open access article distributed under the terms and conditions of the Creative Commons Attribution (CC BY) license (https://creativecommons.org/licenses/by/4.0/).
Share and Cite
Rizk, M.A.; El-Sayed, S.A.E.-S.; Igarashi, I. Effects of Methanolic Extract from Turmeric (Curcuma longa) against the In Vitro Multiplication of Several Babesia Species and Theileria equi. Parasitologia 2021, 1, 188-196. https://doi.org/10.3390/parasitologia1040020
Rizk MA, El-Sayed SAE-S, Igarashi I. Effects of Methanolic Extract from Turmeric (Curcuma longa) against the In Vitro Multiplication of Several Babesia Species and Theileria equi. Parasitologia. 2021; 1(4):188-196. https://doi.org/10.3390/parasitologia1040020
Chicago/Turabian StyleRizk, Mohamed Abdo, Shimaa Abd El-Salam El-Sayed, and Ikuo Igarashi. 2021. "Effects of Methanolic Extract from Turmeric (Curcuma longa) against the In Vitro Multiplication of Several Babesia Species and Theileria equi" Parasitologia 1, no. 4: 188-196. https://doi.org/10.3390/parasitologia1040020
APA StyleRizk, M. A., El-Sayed, S. A. E.-S., & Igarashi, I. (2021). Effects of Methanolic Extract from Turmeric (Curcuma longa) against the In Vitro Multiplication of Several Babesia Species and Theileria equi. Parasitologia, 1(4), 188-196. https://doi.org/10.3390/parasitologia1040020

